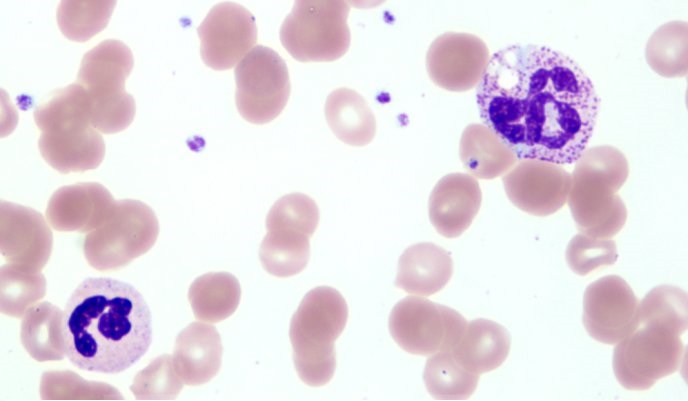
儿童血常规化验单怎么看白细胞,血常规化验单白细胞和超敏关系

现在只要进医院看病,都先让患者化验一下血常规(医学术语叫做血细胞分析)。网上分析血常规结果的帖子也很多,但是很少提到各个项目为什么要化验它们,它们又是怎么得到结果的。现在由我来分析一下。

血常规化验单
首先,血常规就是为了取得血液里的血细胞的相关信息。由于血液里就是三种血细胞,所以化验单上分为三块:白细胞信息(从“白细胞数目”到“嗜碱性粒细胞数目“),红细胞信息(从“红细胞数目”到“红细胞分布宽度标准差”),血小板信息(其余)。
现在说一下白细胞信息(从“白细胞数目”到“嗜碱性粒细胞数目“)
白细胞数目(WBC)是看1L血液里有多少个白细胞,白细胞与抗感染有关,当然骨髓造血出现异常也会有改变。化验方法是把红细胞和血小板用试剂溶解破坏掉,然后数一数剩下的细胞,可以在显微镜下肉眼数,也可以用机器数。机器数就是在管道里流过处理后的血液,每流过一个细胞就会有一个电压变化(电位差),记下电位变化发生多少次就是流过多少细胞。但是有的病人会在血液里出现了不成熟的红细胞,就是骨髓里新生的红细胞还没有把细胞核抛弃掉就进入了血液,这时机器计数就可能把不成熟红细胞也算作白细胞,所以以前常要肉眼人工分析加以修正,现在的机器已经添加了此功能,会在机器显示屏上给出一个大致校正的结果(不会出现在化验单上,只有化验员在后台能知道)。
血液里的白细胞分为五种:中性粒细胞(NE),淋巴细胞(LY),单核细胞(MO),嗜酸粒细胞(EO)和嗜碱粒细胞(BA)。五种细胞各有功能,而且正常情况下占有的比例相对稳定。
血常规分析仪出现以前,把五种白细胞分别计数,要靠一种叫做瑞氏染色的技术:把血液在玻璃片上推开,让血细胞单层平铺,加上瑞氏染液,染色后,五种白细胞的大小、细胞核的颜色形状还有细胞质里面颗粒的大小数量颜色就清楚了,计数100-200白细胞里各有多少个(如下图,大个的是中性粒细胞,可以看见细胞质里有很多颗粒,这就是粒细胞名称的来源,嗜酸粒细胞、嗜碱粒细胞同样)。
现在使用血细胞分析仪,用的染色液是荧光染色液,激光激发出的荧光给出以下信息:体积大小(单核细胞≥三种粒细胞>淋巴细胞),细胞核形状(三种粒细胞分成几块,术语叫分叶,单核细胞是单个核扭曲折叠,淋巴细胞有一圆核),颗粒复杂程度(嗜碱粒细胞颗粒大但少,嗜酸粒细胞又大又多,中性粒细胞多但是小,单核细胞又小又少,淋巴细胞没有颗粒)。由此每个细胞在三维坐标体系中都有一个位置,并且最终形成五个细胞团,分别对应五种细胞。仪器分析几千到几万细胞,算出每种细胞占多少比例,如下图,上中为二维,下为三维。



由于淋巴细胞各种亚型在细胞体积、细胞核、颗粒三方面都相近,所以血细胞分析仪是不能给出淋巴细胞亚群结果的。
有时候患者拿到短期内连续两次报告,发现白细胞的数量相差很大,就怀疑是否做错了。实际上可能不是,因为白细胞数量也是有昼夜节律的,一天内最大值和最小值可以相差一倍。根据粒细胞群发育阶段,人为地分为分裂池、成熟池、贮备池、循环池和边缘池等。前三池的白细胞都在骨髓里;进入外周血的成熟白细胞有一半随血液而循环,称为循环池,白细胞计数值就是循环池的细胞数; 进入外周血的另一半成熟白细胞,粘附于微静脉血管壁,边缘池和循环池粒细胞保持动态平衡,由于多种因素的影响,边缘池和循环池中的粒细胞可一过性地从一方转向另一方,使白细胞计数显示大幅度甚至成倍波动,所以一天内最大值和最小值可以相差一倍。当受到感染时,机体不能等着骨髓现造白细胞,而是把骨髓贮备池的白细胞释放入血液起作用,所以白细胞数升高很快。